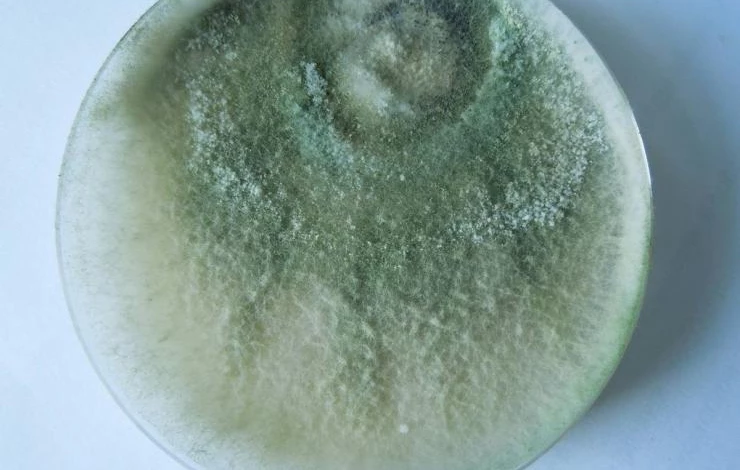
триходерма выращивание в домашних условиях

Триходерма: как вырастить полезный гриб на перловке, перлите, в жидкой и овощной среде
В последнее время последователи здорового питания и любители органического земледелия призывают отказаться от применения химии. Существуют другие альтернативные методы борьбы с вредоносными патогенами различной этиологии. Одним из них является использование биологических препаратов. В статье мы расскажем, как вырастить триходерму (Trichoderma)в домашних условиях и получить эффективное биосредство.
Оглавление
1. Характеристика биосредства2. Применение фунгицида3. Приготовление своими руками 4. Способы выращивания 4.1. На перловке 4.2. В жидкой среде 4.3. На перлите 4.4. В картофельном отваре
Описание триходермы
Под воздействием неблагоприятных условий происходит развитие различных патогенов, наносящих огромный урон аграриям. Нередко из-за массового заражения болезнями или заселения вредителями урожай не удается получить вовсе. Чтобы не допустить этого следует, проводить различные мероприятия: агротехнические, механические, биологические и, конечно же, химические. Однако использование химических резко сокращается.
На рынок выпущено огромное количество натуральных средств, которые не наносят вреда ни растениям, ни живым организмам. Либо же вред этот минимальный. Примером таких препаратов являются биосредства, созданные на основе гриба Триходерма. Звучит, на первый взгляд, страшновато, однако это совсем не так. Познакомимся с этим «страшным зверем».
Триходерма — это полезный для растений микроскопический гриб, который поселяется в почве богатой органикой и питается за счет вредных микробов и продуктами их жизнедеятельности. Эти грибы безвредны, не токсичны и не ядовиты. Основные направления его деятельности:
- улучшает структуру почвы, повышает ее плодородие, принимает участие в гумусообразовании;
- действует как биологический фунгицид. Являясь «хищником» для возбудителей бактериальных и грибковых болезней, гриб выделяет природные антибиотики, которые весьма успешно борются с данными болезнями в начале вегетации растения;
- природный ростостимулятор. Активно способствует мощному росту огородных и садовых растений;
- в значительной степени способствует укреплению иммунитета растений, делая их менее уязвимыми для болезней и помогает противостоять неблагоприятным условиям.
Препараты на основе данного гриба существуют в продаже в различной форме: в растворе и в сухом виде. Препараты на его основе выходят под разными названиями. И находят они все большую популярность. Наиболее часто применяемым препаратом на основе триходермы являются биофунгициды под торговыми названиями: Триходермин, Триходерма вериде, Трихоцин, СП, ТрихоПлант. Первый из них самый известный и востребованный.
Применение триходермы для растений
Садоводы используют триходерму для различных целей:
- Для борьбы с грибными и бактериальными болезнями растений, в том числе и самыми вредоносными: фитофтороз, пероноспороз, черная ножка, альтернариоз, серая гниль и др. Проявляет свои фунгицидные свойства против более 60-ти различных болезней сельскохозяйственных культур.
- В профилактических целях для замачивания семян и обработки различных органов растений для повышения иммунитета.
- Стимулирует рост и развитие как растений в целом, так и отдельных их органов, повышает урожайность.
- Применяется для опрыскивания растений, замачивания семян и клубней, внесения в лунки при посадке рассады, обработки корней перед посадкой растений, обработки почвы в качестве профилактического приема или же в начале проявления признаков болезней.
Условия применения фунгицида
Одно из главных условий для применения фунгицида — соблюдение оптимальных температурных температур для активной жизнедеятельности грибка. Температурные значения варьируют в пределах +10…+30 градусов. Показатели, превышающие эти значения, ухудшают работу препарата, повышение их до +40 градусов может убить гриб совсем.
К сожалению, не все так радужно в данном направлении. Применение данного препарата весьма накладно, хотя и стоит он недорого. Однако количества препарата в магазинных расфасовках хватит всего лишь для небольшого количества растений или однократной обработки небольшой площади. Поэтому закупать следует сразу достаточно много упаковок. Где-то я прочитала, что для хотя бы для разового применения на необходимой площади данного биопрепарата придется затратить около 600 руб. В нынешних условиях, уверена, и того больше.
Поэтому большинство наших дачников приспособились и уже давно и успешно практикуют собственноручное приготовление биологического препарата на основе гриба триходермы. Для этого придется потратиться всего на одну магазинную упаковочку.
Бесплатные способы приготовления триходермы своими руками
Существует и вовсе бесплатный способ приготовления: нужно лишь собрать в лесу грибов-трутовиков, уложить их в пакеты, прочно завязанные, упрятать в темное место и примерно с месяц их не беспокоить. После этого на лесных грибах появится пушистый налет зеленоватого цвета. Это и есть споры гриба триходерма. Остается только соскрести триходерму ножом и растворить в воде. Все, препарат готов к использованию.
Используют еще и по-другому: трутовик перемалывается на мясорубке без ножа и сетки. Полученный состав с успехом применяется как биопрепарат. К сожалению, нормировать применение данного раствора проблематично. Обычно трутовик с триходермой величиной с обычный кусок мыла настаивают в ведре воды, достаточной для обработки двух метров квадратных площади.

Выращивание триходермы в домашних условиях
Использование готового магазинного биопрепарата в домашнем приготовлении данного фунгицида преобладает. Самолично приготовленный препарат не уступает магазинному по своим основным полезным свойствам. Самыми удобными и доступными способами приготовления препарата являются разведение триходермы на определенных средах.
Выращивание триходермы на перловке
Что потребуется: одна упаковка готового триходермина, крупа перловая (0,5 кг).
Приготовление:
- Крупу промыть несколько раз до прозрачности воды и оставить в воде на ночь.
- Утром набухшую перловку без воды поместить в стерилизованную поллитровую банку и отправить в микроволновку на 10 минут для уничтожения возможных дрожжевых спор.
- Как только крупа остынет, добавить две столовых ложки готового грибного препарата или около 100 г.
- После плотного, но не герметичного обвязывания банки с содержимым бумагой ее помещают в тепло без доступа света.
- Через пару дней на поверхности содержимого внутри можно будет наблюдать грибной мицелий белой плесени. Еще через пару дней на ее поверхности появятся зеленоватые споры.
Ошибки, совершаемые при данном методе:
- Переваренная крупа.
- Герметичное закупоривание банки. Гриб развивается в аэробных (с доступом воздуха) условиях.
- Несоблюдение условий хранения. Хранить в холодильнике не более трех месяцев.
- Отсутствие белой плесени и зеленоватых спор после всех сроков ожидания. Причина — фальсифицированный купленный препарат. Придется купить новый в другом месте.
Важно
Неиспользованную смесь можно хранить в холодильнике не более трех месяцев. Высушивание или замораживание гриба также не ухудшит его полезные свойства, но продлит сроки использования.

Выращивание триходермы в жидкой среде
- В литровой банке с кипяченой остуженной водой следует растворить доступное комплексное удобрение в строгом соответствии с прилагаемой инструкцией.
- Нужно добавить чайную ложечку растворенного сахара и всыпать чайную ложку триходермина.
- Размешать, накрыть марлей или бумагой негерметично и поместить в теплое, с температурой +20…+25 градусов, темное место.
- Для ускорения процесса грибообразования можно периодически помешивать стерильной ложечкой. Обычно для окончания процесса достаточно 10 суток.
Важно
Использовать необходимо только стерильные емкости и подручные инструменты.
Применение:
- 100 мл приготовленного жидкого концентрата растворить в 10 л воды;
- 2/3 стакана окутанного мицелием зерна размешайте в ведре с водой и оставьте на какое-то время, лучше на ночь. После хорошего перемешивания можно применять для полива растений.
- Рекомендация. Для применения в опрыскивателях грибной субстрат необходимо размешать и процедить.

Выращивание триходермы на перлите
Перлит — это горная порода вулканического происхождения, которая, благодаря хорошей пористости, способна к впитыванию жидкости, в 4 раза превышающей собственную массу. Перлит имеет нейтральную среду, позволяющую использовать его для различных целей, к примеру, для подготовки почвенного грунта под рассаду. Установлено также, что перлит является хорошей средой для выращивания триходермы.
Процесс приготовления:
- Для начала процесса необходима прозрачная емкость с плотной крышкой. Такой выбор необходим для наблюдения за прохождением полного процесса зарождения грибного мицелия.
- В выбранную банку насыпьте перлит, оставляя свободным 2–3 см до краев.
- Теперь готовим питательную смесь: в разведенное по инструкции в отстоявшейся воде любое минеральное удобрение, лучше жидкое (потребуется 1 л раствора), добавить щепотку обычной соли и ложку столовую сахара.
- После этого для равномерного пропитывания перлитных гранул раствором банку необходимо хорошо встряхнуть и оставить для скапливания жидкости на дне емкости, которой при правильной подготовке должно быть около 1 см.
- Сверху на гранулы выкладывается магазинный «полуфабрикат» триходермы.
- Теперь банка закрывается и устанавливается в тепло в темное место. Затем периодически банку следует слегла переворачивать для равномерного постепенного пропитывания гранул раствором, отстоявшимся на дне.
- Жидкость по порам будет подниматься кверху, достигая разрастающегося там грибного мицелия и давая ему питание.
- Раз в неделю грибам следует подавать свежий воздух, для чего на ночь оставить крышку приоткрытой. Хранят такие банки в темноте, где она прекрасно сохраняет свои свойства в течение нескольких месяцев.

Выращивание триходермы на картофельном отваре
Некоторые дачники в качестве питательной среды применяют отвары картофеля или любых овощей. Подготовка проходит аналогично предыдущему способу выращивания триходермы, с заменой перлита на жидкую среду в виде отвара. Однако, честно говоря, положительных отзывов с удачным результатом ни от опытных дачников, ни в литературе, ни на просторах интернета я нашла крайне немного. Отчего можно сделать вывод о наибольших перспективах первых трех способов.
Важно
Нужно покупать Триходермин качественный, настоящий от проверенного поставщика и правильно его хранить. Целостность упаковки позволяет хранить его до трех лет. Порошковый препарат после открывания упаковки быстро теряет свои свойства. Не рекомендуется использовать препараты на основе триходермы одновременно с пестицидами. Химия подавляет действие триходермы.

______________________________________________________________________________________________
Читайте другие наши статьи о субстратах и удобрениях :
Почвоулучшители для рассады: какие добавки применять для повышения качества грунта
Выращивание рассады на кокосовом субстрате
Вермикулит для растений: используем субстрат во благо рассады, комнатных цветов и культур на грядках
Азофоска: как, когда и для чего применять эффективное удобрение
______________________________________________________________________________________________
А вы выращиваете триходерму? Поделитесь отзывами и рекомендациями с другими садоводами в комментариях.
5 вопросов от экспертов проекта «Антонов сад»!
Подпишитесь на рассылку Антонов сад и получайте каждую неделю новые статьи и советы по выращиванию.
Комментарии (17)

















